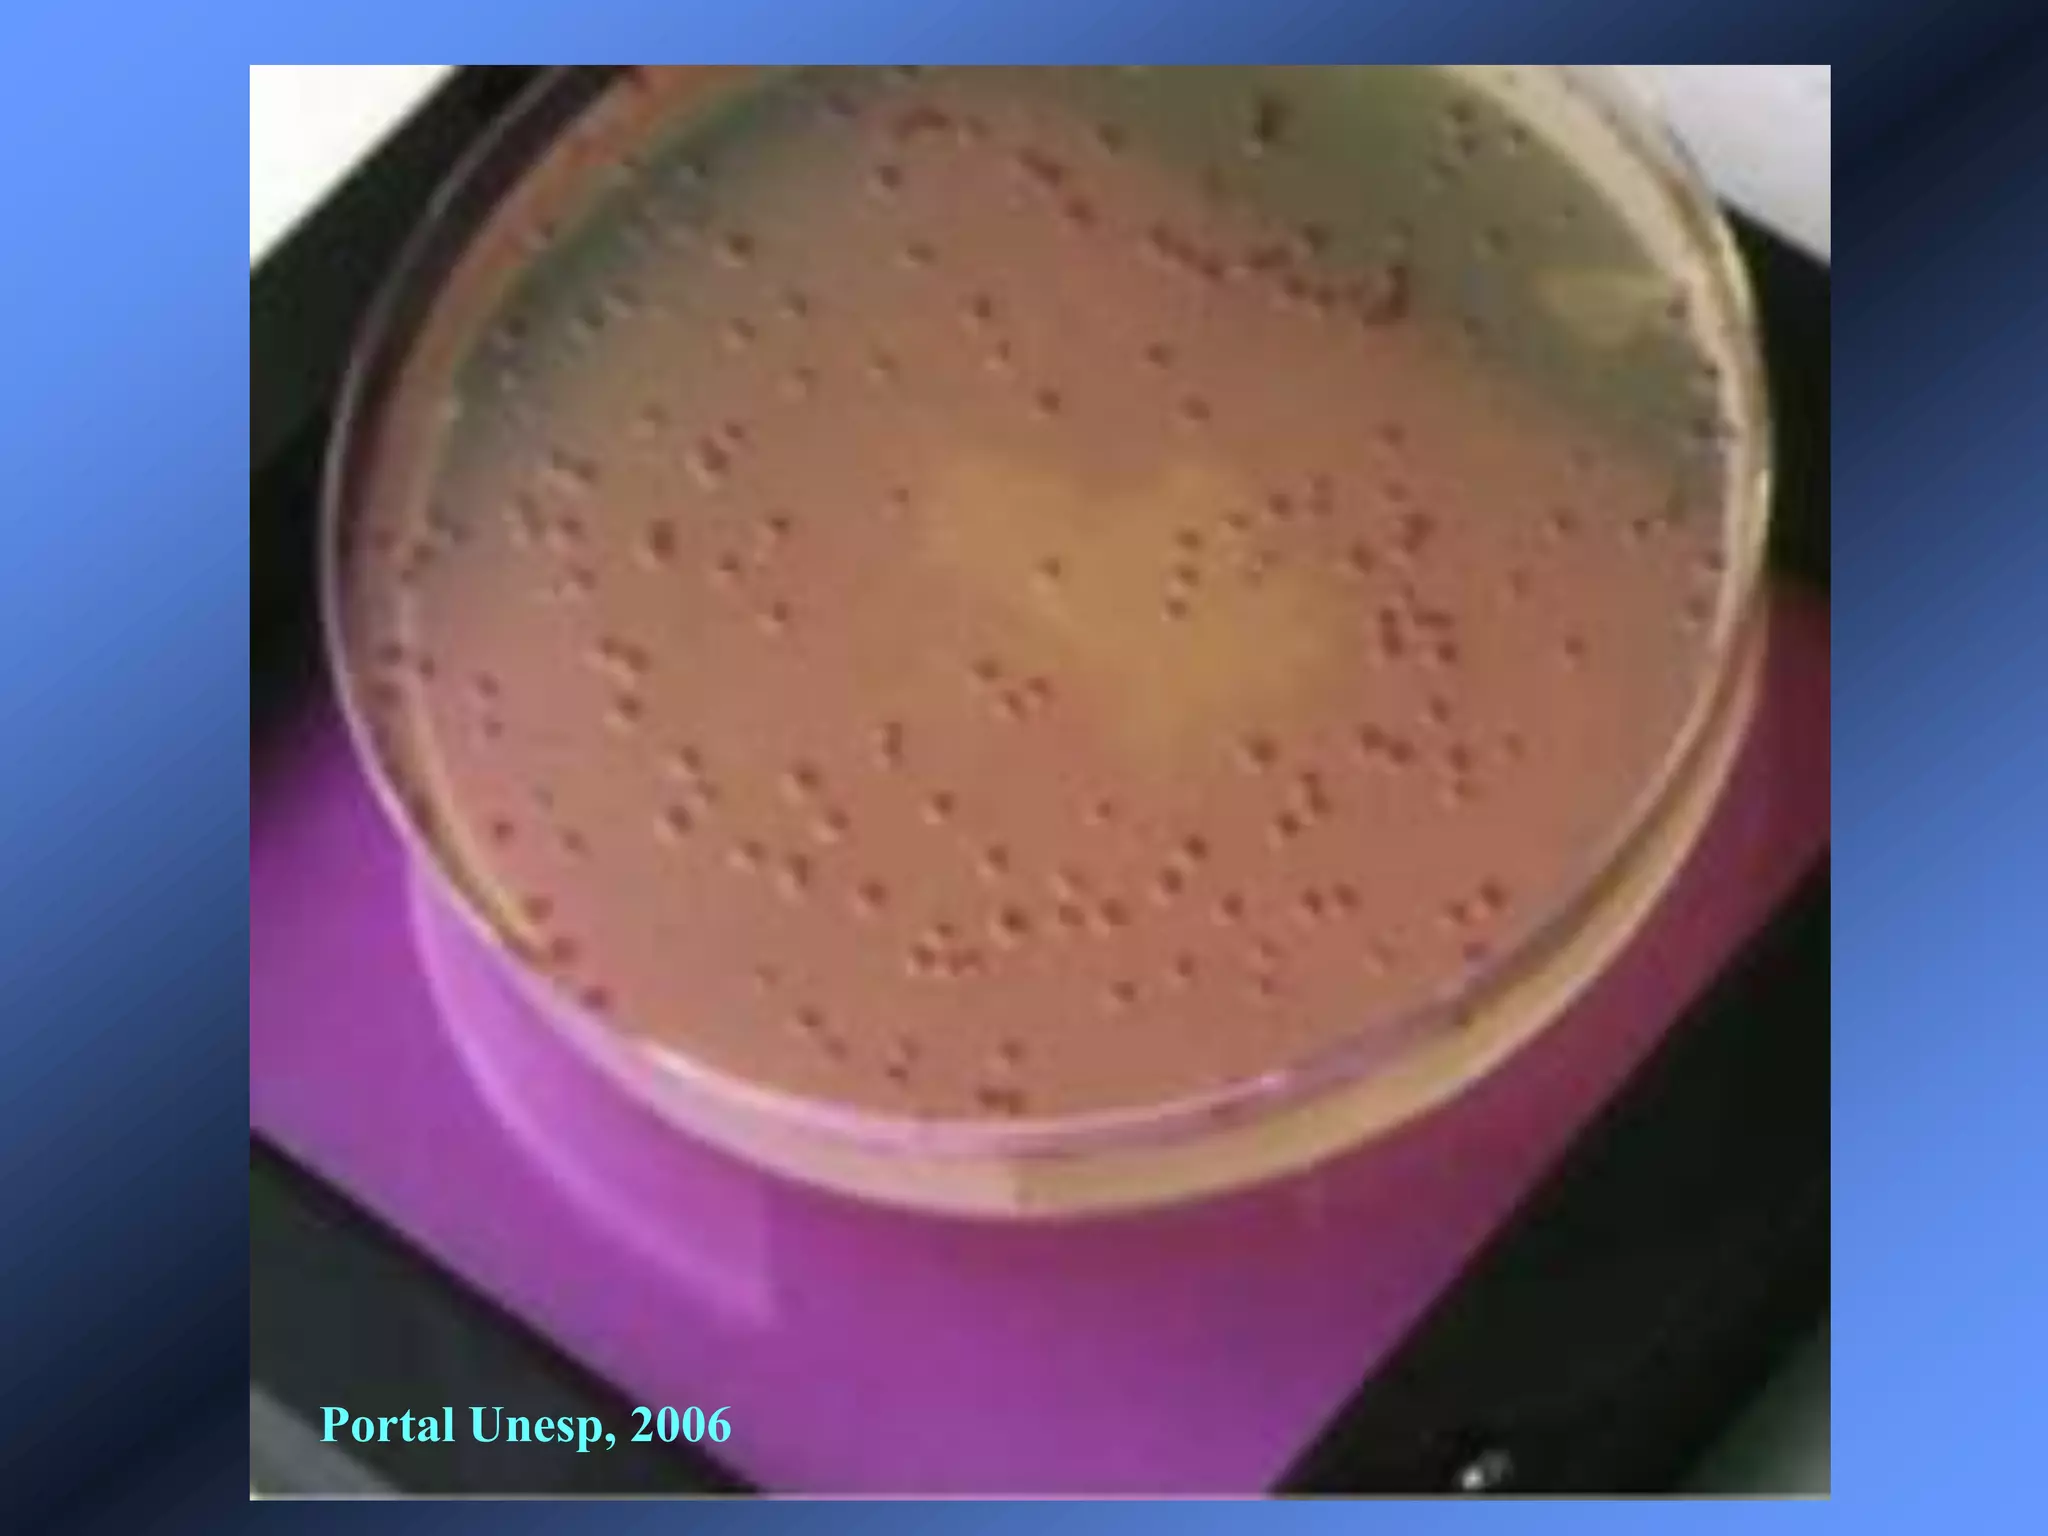
Portal Unesp, 2006

Incorporar apresentação































Estudos in vitro, modelos animais e relatos de caso na Área de Saúde. O documento discute diferentes tipos de estudos científicos na área da saúde, incluindo estudos in vitro, modelos animais e relatos de caso, citando várias referências bibliográficas como exemplos destes métodos.